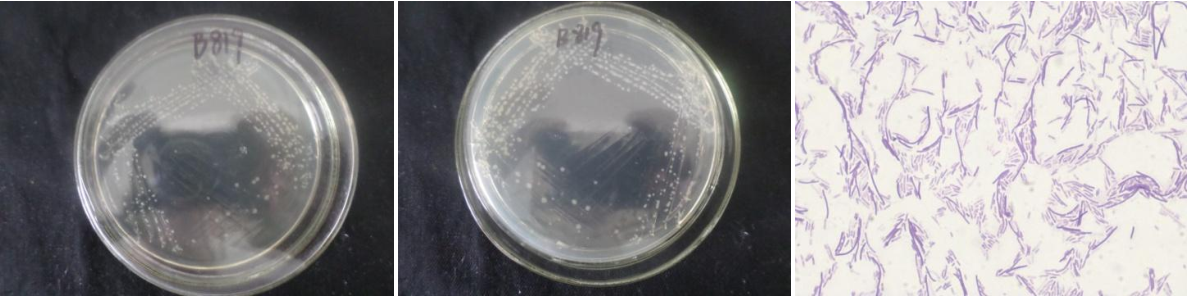

Loading...
| StrainNO | B819 |
| Classification | Brevibacillus |
| 16s rDNA sequence | TCGAGCGAGTCTCTTCGGAGGCTAGCGGCGGACGGGTGAGTAACACGTAGGCAACCTGCCTCTCAGACTGGGATAACATAGGGAA ACTTATGCTAATACCGGATAGGTTTTTGGATCGCATGATCCGAAAAGAAAAGATGGCTTCGGCTATCACTGGGAGATGGGCCTGC GGCGCATTAGCTAGTTGGTGGGGTAACGGCCTACCAAGGCGACGATGCGTAGCCGACCTGAGAGGGTGACCGGCCACACTGGGAC TGAGACACGGCCCAGACTCCTACGGGAGGCAGCAGTAGGGAATTTTCCACAATGGACGAAAGTCTGATGGAGCAACGCCGCGTGA ACGATGAAGGTCTTCGGATTGTAAAGTTCTGTTGTTAGGGACGAATAAGTACCGTTCGAATAGGGCGGTACCTTGACGGTACCTG ACGAGAAAGCCACGGCTAACTACGTGCCAGCAGCCGCGGTAATACGTAGGTGGCAAGCGTTGTCCGGATTTATTGGGCGTAAAGC GCGCGCAGGCGGCTATGTAAGTCTGGTGTTAAAGCCCGGGGCTCAACCCCGGTTCGCATCGGAAACTGTGTAGCTTGAGTGCAGA AGAGGAAAGCGGTATTCCACGTGTAGCGGTGAAATGCGTAGAGATGTGGAGGAACACCAGTGGCGAAGGCGGCTTTCTGGTCTGT AACTGACGCTGAGGCGCGAAAGCGTGGGGAGCAAaCAGGATTAGATACCCTGGTAGTCCACGCCGTAAACGATGAGTGCTAGGTG TTGGGGGTTTCAATACCCTCAGTGCCGCAGCTAACGCAATAAGCACTCCGCCTGGGGAGTACGCTCGCAAGAGTGAAACTCAAAG GAATTGACGGGGGCCCGCACAAGCGGTGGAGCATGTGGTTTAATTCGAAGCAACGCGAAGAACCTTACCAGGTCTTGACATCCCG CTGACCGCTCTGGAGACAGAGCTTCCCTTCGGGGCAGCGGTGACAGGTGGTGCATGGTTGTCGTCAGCTCGTGTCGTGAGATGTT GGGTTAAGTCCCGCAACGAGCGCAACCCTTATCTTTAGTTGCCAGCATTCAGTTGGGCACTCTAGAGAGACTGCCGTCGACAAGA CGGAGGAAGGCGGGGATGACGTCAAATCATCATGCCCCTTATGACCTGGGCTACACACGTGCTACAATGGTTGGTACAACGGGAT GCTACCTCGCGAGAGGACGCCAATCTCTTAAAACCAATCTCAGTTCGGATTGTAGGCTGCAACTCGCCTACATGAAGTCGGAATC GCTAGTAATCGCGGATCAGCATGCCGCGGTGAATACGTTCCCGGGCCTTGTACACACCGCCCGTCACACCACGGGAGTTTGCAAC ACCCGAAGTCGGTGAGGTAACCGCAAGGAGCC |
| Strain Morphology Photos | |
| Morphological Description | Colony round;Lychee flesh white;edge serrated;Slightly concave in the middle;multifold;slippy;sticky;thin;translucent;Rod;having spore;Mesophilic budding spore |